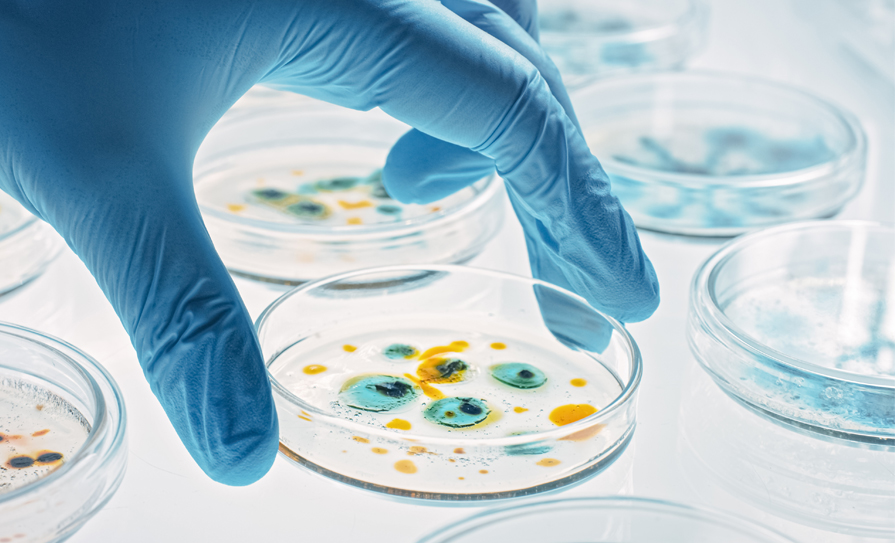

The new patient-focused app from Clanwilliam will support the digital transformation plans of general practices across Ireland.
Over the last two years, we have witnessed the growing importance of digital technologies to our health services. During this time, it has become increasingly clear why we need to harness these technologies to make those same services more agile, flexible and responsive, for the benefit of both healthcare professionals and their patients.

While before the pandemic, digital maturity may have been considered a ‘nice to have’ for health services, its necessity for health service providers is now widely understood, with an expectation from patients around ease and efficiency of use that arguably did not exist before Covid-19.
Digital transformation journey
At Clanwilliam, we’ve been pioneering the use of technology in health for over a quarter of a century. Our founding objective, some 25 years ago, was to improve connectivity, efficiency and transparency in healthcare settings. From technology for nursing homes to revenue cycle management software for hospitals, technology has played a major role in helping us to achieve that goal ever since.
Free to use, the app will allow patients to book, cancel, reschedule and pay for their appointment online
When Covid-19 emerged, thankfully we were able to pivot many of the functionalities and systems we’d been developing to adapt to the needs of this unprecedented health crisis. To support our healthcare frontline workers, we rose to this challenge by accelerating our development roadmap and prioritising new functionality that would help our users to fight the pandemic for us all.
From e-prescriptions to e-referrals and video consultations, we innovated at speed to ensure that our customers were equipped with the solutions they required to deliver to meet patient needs during those challenging times. The end result was that in a very short period, millions of people came to realise the true value of healthcare technology, and our software and services in particular.
The task now is to keep this momentum going by building sustainable, trusted services that facilitate doctor-patient interactions in a simple, effective, and reliable way.
Pippo – a patient-focused app
That’s why we’re delighted to launch the pilot of our latest innovation this month – Pippo. Our new patient portal app, Pippo will enable the digital transformation plans of GPs across Ireland, helping to make day-to-day interactions with their patients as seamless and straightforward as possible.
Free to use, the app will allow patients to book, cancel, reschedule and pay for their appointment online. Pippo will also enable them to meet their GP remotely via video consultation, helping to make health check-ups more efficient and save valuable time. Meanwhile, for practices, the app will free up valuable resources by reducing the number of inbound calls, as well as the time it takes to receive payment directly from a patient.
The portal is also designed to fully integrate with GPs’ existing practice management systems (Socrates and Helix Practice Management) to eliminate double entry or double diary management and is fully GDPR compliant. And, built using security and privacy by design, Pippo will give patients and practitioners peace of mind at all times that their data is safe and secure.
Accelerating the pace of digital transformation
At Clanwilliam, we will continue to develop the range of functionalities offered by Pippo in the coming months. This will include the addition of repeat prescription ordering and patients’ electronic health records — all of which will be available directly within the app.
As noted by HIQA, patient summaries or electronic health records are vital for creating a truly joined-up healthcare service. From ensuring the safe and effective treatment of a patient receiving unscheduled care to supporting information sharing, the potential benefits are substantial. After 10 years of development, we’re excited that Clanwilliam will soon be in a place where it can provide this shift in service to healthcare practitioners and patients through the power of technology.
Game-changer
As the first app of its kind to be launched in Ireland, we believe that Pippo will be a game-changer when it comes to transforming the future of GP-patient services.
Ever wanted to make a GP appointment but haven’t had the time or privacy to make a phone call? Ever been put on hold or not been able to get through? Or maybe you’ve forgotten your wallet at the doctor’s office? Pippo will cover patients for all of these eventualities, helping to make GP appointments quicker, easier and more convenient.
Critically, Pippo will also support wider efforts by Government to accelerate digital transformation across our health services. As a long-standing partner to the HSE in the implementation of its Stay Left, Shift Left – 10X strategy, we want to empower the type of innovations and improvements that will allow us all to benefit from doing healthcare 10X better, faster, cheaper and at increased capacity.
With its focus on seamless, secure and efficient patient-GP interactions, as well as the promise of future exciting innovations, through the launch of Pippo, we want to help to make this ambition a reality, while moving one step closer to realising our own vision of a fully connected healthcare system for all.
Pippo can only be used currently by registered patients of practices using the app. Pippo will be made freely available to all Socrates and Helix Practice Manager users in Ireland in early 2023.
To learn more about Pippo, visit: www.pippo.ie

Leave a Reply
You must be logged in to post a comment.